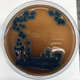

Projects
Rnp A
 Our laboratory is developing novel chemical classes of small molecule inhibitors of the RnpA protein that may represent a novel dual functional antimicrobial target.
Our laboratory is developing novel chemical classes of small molecule inhibitors of the RnpA protein that may represent a novel dual functional antimicrobial target.
PBP4
 Methicillin-resistant Staphylococcus aureus (MRSA) is a global healthcare concern. Our lab is identifying and characterizing PBP4 specific small molecules, as these PBP4-inhibitors showed potential to restore β-lactam susceptibility against MRSA and inhibit recurrent bone infections.
Methicillin-resistant Staphylococcus aureus (MRSA) is a global healthcare concern. Our lab is identifying and characterizing PBP4 specific small molecules, as these PBP4-inhibitors showed potential to restore β-lactam susceptibility against MRSA and inhibit recurrent bone infections.
Luedemann Natural Product Discovery
We have screened a library of over 2000 species of Geodermatophilus desert bacteria and identified five highly promising candidates that may produce novel antimicrobial molecules.
We have screened a library of over 2000 species of Geodermatophilus desert bacteria and identified five highly promising candidates that may produce novel antimicrobial molecules.
Learn more about Luedemann Natural Product Discovery
Efflux Pumps
 Acinetobacter baumannii are drug resistant in the presence of human conditions due to efficient efflux pumps that force the antibiotics out of the cell. Our lab is designing efflux pump inhibitors (EPIs) to restore susceptibility.
Acinetobacter baumannii are drug resistant in the presence of human conditions due to efficient efflux pumps that force the antibiotics out of the cell. Our lab is designing efflux pump inhibitors (EPIs) to restore susceptibility.
Combinatorial Antibiotic Therapy
 To combat the growing issue of bacterial resistance, we combine already FDA approved drugs and create highly synergistic combinations that exceed the efficacy of both the individual antibiotic and also traditional gold standard drugs.
To combat the growing issue of bacterial resistance, we combine already FDA approved drugs and create highly synergistic combinations that exceed the efficacy of both the individual antibiotic and also traditional gold standard drugs.